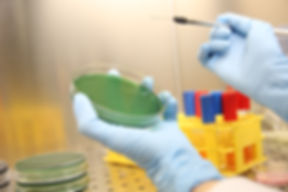

About us
Company Background
Enviro Labs Ltd. (ELL) is a HOKLAS-accredited testing laboratory based in Hong Kong, specializing in the analysis of environmental, food, Chinese medicine, pharmaceutical, and cosmetic samples. Since our establishment in 1994, we have been committed to delivering reliable and professional testing services to a broad spectrum of clients, including government bodies, consultants, small businesses, large enterprises, and the general public.
Our expertise spans a wide range of testing services, including environmental monitoring, food safety, pharmaceutical compliance, Chinese medicine safety, and cosmetic product quality. Equipped with state-of-the-art instruments such as LC-MS/MS, GC-MS, HPLC, ICP-MS, ICP-OES, and FIA, our team of experienced chemists, microbiologists, and engineers ensures that every analysis meets international standards and customer requirements.
At ELL, our quality objectives are to deliver precise and high-quality testing services, continually improve our capabilities, and exceed customer expectations.
Vision
To be recognized as a leading provider of world-class laboratory testing services, offering unparalleled analytical expertise to our customers.
Mission
To safeguard the environment and public health by delivering accurate testing results and expert scientific advice.
關於我們
公司背景
環境化驗有限公司(Enviro Labs Ltd., ELL)是一家位於香港並獲得 HOKLAS 認可的專業測試化驗所,專注於環境、食品、中西藥 及 化妝品樣本的檢測分析。自1994年成立以來,我們致力於為客戶提供可靠且專業的測試服務,客戶群涵蓋政府機構、顧問公司、中小企業、大型企業及公眾人士。
我們的服務範疇涵蓋環境監測、食品安全、藥品合規性檢測、中藥安全 以及化妝品品質分析。實驗室配備尖端設備,包括LC-MS/MS、GC-MS、HPLC、ICP-MS、ICP-OES及FIA等,並由經驗豐富的化學家、微生物學家及工程師組成的團隊,確保每一項分析均符合國際標準和客戶要求。
ELL秉承提供高品質測試服務、不斷自我提升,並滿足甚至超越客戶期望的質量目標。
願景
成為世界領先的實驗室測試服務供應商,為客戶提供卓越的分析專業技術。
使命
通過準確的檢測結果和專業的科學建議,保護環境與公眾健康。


Address
Rm. 510, 610-612, Hong Leong Plaza, 33 Lok Yip Road, Fanling, N.T.,
Hong Kong
Phone
+852 2676 2983
Fax
+852 2676 2860